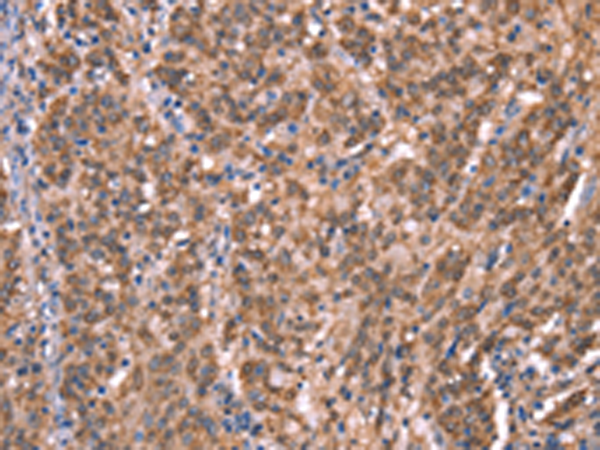

-
分类: 科研抗体货号: P04896别名: HGAL; GCAT2; GCET2应用: IHC反应种属: Human
-
分类: 科研抗体货号: P04893别名:应用: WB,IHC反应种属: Human, Mouse
-
分类: 科研抗体货号: P04845别名: p43; HLD3; EMAP2; SCYE1; EMAPII应用: WB,IHC反应种属: Human, Mouse
-
分类: 科研抗体货号: P04945别名: HH3R; GPCR97应用: WB,IHC反应种属: Human, Mouse
-
分类: 科研抗体货号: P04892别名: AL4; CT4.7; GAGE7B; GAGE-7B应用: WB,IHC反应种属: Human
-
分类: 科研抗体货号: P04841别名: NS4EB; NSE4B; NSMCE4B应用: WB,IHC反应种属: Human, Mouse
-
分类: 科研抗体货号: P04943别名: H1-R; hisH1应用: WB,IHC反应种属: Human
-
分类: 科研抗体货号: P04890别名: GB1; GPRC3A; GABABR1; GABBR1-3; dJ271M21.1.1; dJ271M21.1.2应用: IHC反应种属: Human, Mouse, Rat
-
分类: 科研抗体货号: P04840别名: DYN2; CMT2M; DYNII; LCCS5; CMTDI1; CMTDIB; DI-CMTB应用: WB,IHC反应种属: Human, Mouse, Rat
-
分类: 科研抗体货号: P04940别名: HRASLS2; PLAAT-2; PLA1/2-2应用: IHC反应种属: Human

鄂公网安备42018502007531号
鄂公网安备42018502007531号

